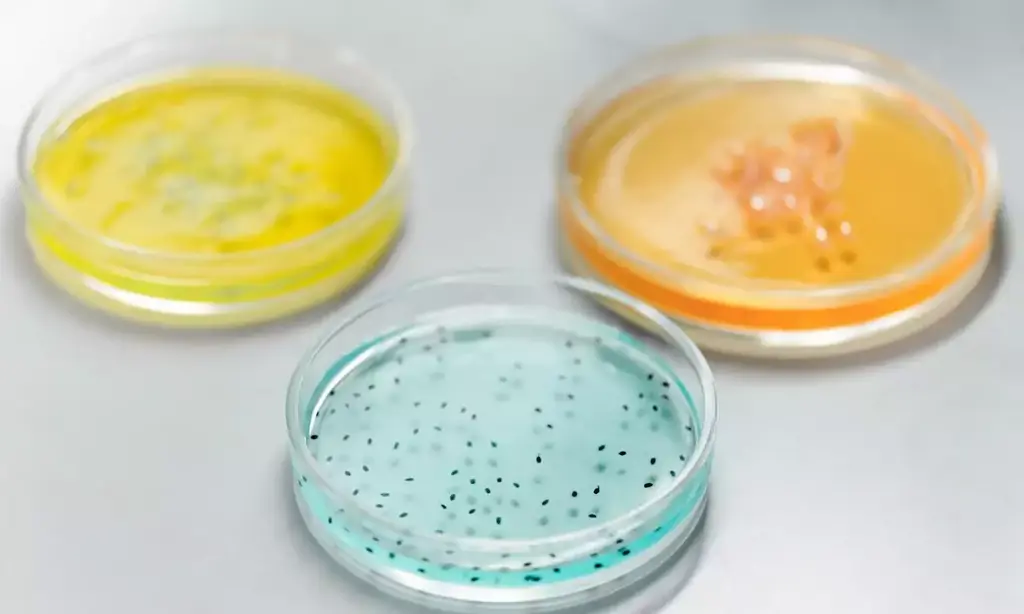
Batteri sensibili al D-mannosio

Convenzioni per i soci
Il D-mannosio è uno zucchero estratto da alberi a legno duro come la betulla, che ha rivelato ottima efficacia contro la cistite.
Agisce legandosi alle zampe dei batteri (lectine), impedendo loro di attaccarsi alla vescica. Senza attecchimento alle pareti vescicali i batteri restano innocui e non scatenano l'infiammazione.
Tuttavia non tutte le lectine batteriche però sono sensibili all'azione del D-mannosio e l'efficacia dipende dal tipo di batterio responsabile dell'infezione.
In sintesi il D-mannosio è efficace contro:
- gli Escherichia coli (responsabili di circa l'80% delle infezioni urinarie)
- la Klebsiella
- la Shigella
- la Salmonella
Dalle esperienze riportate nel nostro forum abbiamo constatato che anche altri batteri sono sensibili al D-mannosio:
Sebbene anche le cistiti da Proteus siano state debellate con solo D-mannosio, abbiamo appurato che questo batterio è meno sensibile al mannosio rispetto ad atri, pertanto si è rivelato necessario aumentare i dosaggi e prolungare la cura, evitando ogni prodotto alcalinizzante poiché l'ambiente ideale del proteus è alcalino.
- Batteri con lectine sensibili al D-mannosio
- Batteri privi di lectine non sensibili al D-mannosio
- Batteri con lectine non sensibili al D-mannosio
Batteri con lectine
Quali batteri sono sensibili al D-mannosio?
Le lectine sensibili al mannosio sono quelle di tipo 1, che possono essere ad alto legame col mannosio (M1H) o a basso legame (M1L). L'80% degli Escherichia coli isolati nell'intestino hanno lectine di tipo M1L, mentre il 70% di quelli isolati nelle urine sono di tipo M1H. I batteri che possiedono questo tipo di lectine mannosio sensibili, oltre agli E.coli sono:
- klebsiella
- shigella
- salmonella
In corso di terapia con D-mannosio è frequente assistere alla comparsa nelle urine di batteri diversi dagli E. coli (Enterococchi, Proteus, ecc). Ciò avviene perchè inizialmente vengono eliminati i batteri con lectine mannosio altamente sensibili (M1H). Se però i fattori predisponenti non vengono eliminati i batteri continueranno ad arrivare. Questi nuovi batteri, visto che non sono stati eradicati dal D-mannosio, molto probabilmente hanno:
- lectine mannosio lievemente sensibili (M1L)
- lectine mannosio insensibili
Nel primo caso (M1L) sarà sufficiente aumentare il dosaggio di D-mannosio e gli intervalli di somministrazione. Nel secondo caso (vedi più avanti) sarà necessario ricorrere ad altre cure.
Nathan Sharon del dipartimento di chimica biologica dell'istituto di scienze Weitzmann israeliano ritiene che in un futuro imminente non sarà più necessario combattere le infezioni con terapie antibiotiche, che verranno sostituite con terapie a base di zuccheri. E questo sarà valido sia per la vescica, che per tutti gli altri organi del nostro organismo. Egli sostiene che questo tipo di terapia antiadesiva sarà più efficace degli antibiotici, sarà priva di effetti collaterali significativi, non sarà tossica, non creerà danni alla flora batterica e non debiliterà il sistema immunitario, poiché si tratta di sostanze presenti normalmente nel nostro organismo. Sharon spiega che il latte umano contiene oligosaccaridi (zuccheri complessi) in altissime concentrazioni e che molti di questi hanno capacità elevate di aderire alle lectine batteriche. I bambini allattati al seno hanno un'incidenza nettamente inferiore di diarree da campylobacter jejuni rispetto a quelli nutriti con latte artificiale.
Sharon afferma inoltre che questo tipo di terapia, non uccidendo i batteri come fanno gli antibiotici (lasciando in vita quelli più resistenti, che genereranno figli altrettanto forti) non crea resistenze, ma anzi consente una maggior sensibilità dei batteri agli stessi antibiotici.
In effetti è molto frequente nelle donne che assumono D-mannosio riscontrare nell'antibiogramma un notevole aumento della sensibilità da parte dei batteri, persa dopo anni di terapie antibiotiche.
Convenzioni per i soci
Scopri il D-mannosio consigliato dall'associazione
Batteri privi di lectine
Quali batteri non sono sensibili al D-mannosio?
Esistono poi batteri sprovvisti di lectine. Il D-mannosio ovviamente non è attivo su questi batteri e non riuscirà ad eliminarli. Essi concepiranno figli uguali a loro (quindi senza “zampe”), che colonizzeranno le urine sostituendosi gradualmente ai batteri con lectine. Ciò non deve assolutamente preoccupare. Infatti senza lectine i batteri non riescono ad attaccarsi ai mastociti presenti sulle mucose uroteliali (i mastociti sono cellule immunitarie responsabili dell'attivazione del processo infiammatorio) e quindi non potranno provocare ne' infiammazione, ne' dolore, ne' danno. È frequente infatti in corso di terapia con D-mannosio avere:
- urina torbida, maleodorante, e piena di nitriti (segno di presenza batterica)
- urinocolture positive senza però leucociti (indice di infiammazione)
- assenza di sintomi significativi
Questa batteriuria non va trattata proprio perchè non solo è innocua, ma addirittura protettiva! Infatti la presenza di questi batteri toglie spazio vitale e sostanze nutritive a quelli aggressivi impedendogli di colonizzare la vescica.
Batteri con lectine non sensibili
Quali batteri con lectine non sono sensibili al D-mannosio?
Esistono infine lectine di tipo P, insensibili al mannosio perchè non in grado di legarsi ad esso. Questi batteri quindi non aderiscono al mannosio presente sulle mucose vescicali, ma si legano ad altri elementi presenti sull'urotelio (il tessuto urinario). Le lectine P sembrano avere maggior potere di provocare infiammazione e sono le responsabili delle pielonefriti, probabilmente perchè sono insensibili anche all'azione difensiva di IgA e proteine di Tamm Horsfall e quindi riescono a risalire incontrastati fino al rene.
Laddove il D-mannosio risultasse inefficace è probabile che l'infezione sia provocata da batteri che presentano lectine mannosio insensibili o lectine a basso legame col mannosio. Fortunatamente a livello urinario la maggioranza dei batteri implicati nelle infezioni sono di tipo 1 ad alto legame, seguiti da quelli a basso legame e raramente sono coinvolti batteri mannosio insensibili.
Grazie a recenti studi pare che questi batteri mannosio insensibili siano in grado di legarsi ad altri zuccheri quali:
- il galabiosio
- il fucosio
- lo xylitolo
e ad altre sostanze quali le proantocianidine di tipo A (PAC-A) estratte dal mirtillo rosso (cranberry).
Proprio per questo motivo Cistite.info APS, realtà di riferimento in Italia per la prevenzione e il trattamento naturale dei disturbi uro-genitali che mette a disposizione professionisti esperti e corsi pensati per migliorare il benessere intimo, ha fatto produrre un D-mannosio purissimo potenziato da Xylitolo e Oximacro (l'estratto con la maggior quantità di PAC di tipo A presente sul mercato).
Leggi maggiori informazioni su Puroman ACT
La ricerca sta cercando di sintetizzare chimicamente sostanze costituite da più tipi di zuccheri diversi tra loro uniti in un'unica molecola, affinchè siano efficaci su tutti i tipi di lectine batteriche (talvolta presenti anche su un unico batterio) in modo da rendere la terapia ancora più efficace dello zucchero singolo ed in grado di sostituire completamente gli antibiotici anche per patologie diverse da quelle urinarie. Infatti sono in corso numerosi studi sul ruolo del D-mannosio non solo sulle infezioni urinarie, ma anche su infezioni in altri organi del corpo. Infatti la terapia antiadesiva a base di zuccheri in studi effettuati su animali sembra essere efficace, oltre che contro questi uropatogeni mannosio-insensibili, anche contro la neisseria gonohorreae (responsabile di malattie genitali sessualmente trasmissibili) e l'Helicobacter pylori (responsabile di gastrite ed ulcera gastrica).
Bibliografia
- “Women's Encyclopedia of Natural Medicine", Tori Hudson, McGraw-Hill 2008, pag 70
- "Effect of D-mannose and D-glucose on Escherichia coli bacteriuria in rats", Michaels E, Chmiel J, Plotkin B, Schaeffer A., Urol Res. 1983;11:97-102
- "Scaglione F, Minghetti P, Ambrosio F, Ernst B, Ficarra V, Gobbi M, Naber K, Schellekens H. Nature of the Interaction of Alpha-D-Mannose and Escherichia coli Bacteria, and Implications for its Regulatory Classification. A Delphi Panel European Consensus Based on Chemistry and Legal Evidence. Ther Innov Regul Sci. 2023 Nov;57(6):1153-1166. doi: 10.1007/s43441-023-00548-8. Epub 2023 Aug 14. PMID: 37578736; PMCID: PMC10579141.", https://pubmed.ncbi.nlm.nih.gov/37578736/
- “Synthetic Multimeric Heptyl Mannosides as Potent antiadhesives of uropathogenic escherichia coli” ChemMedChem 2009, 4, 749 – 755